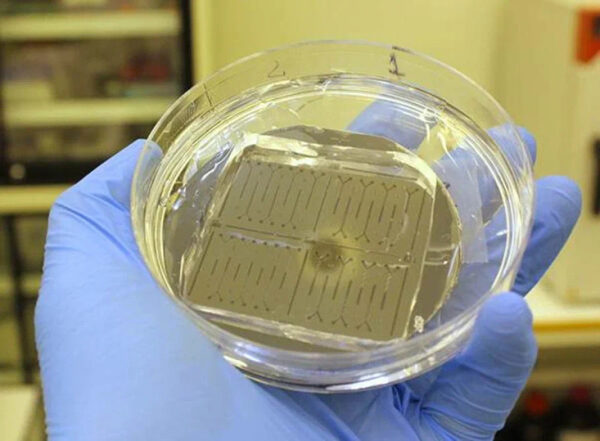
Российские ученые разработали сенсор для быстрого определения признаков старения 2 Российские ученые создали сенсор для мгновенного выявления признаков старения

Признаки старения научились выявлять за доли секунды специальным сенсором
Российские ученые научились за доли секунды «вычислять» активные формы кислорода в плазме крови или слюне, то есть, определять по ним степень старения организма. Для этого они создали специальный небольшой сенсор – «чип» с микроканалами, который выдает быстрый и стопроцентный результат за счет очень эффективного перемешивания биологической жидкости с выявляющим свободные радикалы веществом. Результаты исследования, о котором сообщает РНФ, опубликованы в журнале Microchemical Journal.

тестовый баннер под заглавное изображение
Активные формы кислорода (те самые радикалы, ускоряющие старение) могут накапливаться в организме из-за курения, употребления алкоголя, вдыхания загрязненного воздуха, хронических заболеваний и других причин.
Если их накапливается много, может начаться процесс повреждения белков, появиться риск развития всевозможных воспалительных процессов, болезней мозга, сердечно-сосудистой системы, и в конце концов организм начнет ускоренно стареть.
Чтобы «поймать» процесс накопления активных форм кислорода на ранней стадии, медики научились оценивать их уровень в организме. К примеру, в их арсенале уже есть устройства, в которых кровь или слюна пациента свободно смешиваются со светящимся веществом люминолом в специальных небольших лунках. Если свободных радикалов много, люминол подсвечивает их. Процесс этот, по словам одного из авторов работы, инженера-исследователя Международного научно-образовательного центра физики наноструктур Университета ИТМО Глеба Симоненко, занимает минуты и не всегда дает корректный результат из-за медленного перемешивания.

Чтобы решить проблему, исследователи из ИТМО, Санкт-Петербургского академического университета имени Ж.И. Алферова РАН и Института аналитического приборостроения РАН создали более чувствительный микрофлюидный чип. Это миниатюрное устройство, где люминол и биологическая жидкость проходят через микроканалы со специальным рельефом. Этот рельеф, разработанный методом математического моделирования физических процессов, разделяет жидкости, прогоняет по разным каналам, тем самым ускоряя их смешивание в разы. В итоге смесь образца плазмы крови или слюны (их требуется меньше капли) попадает в зону, где специальный датчик измеряет уровень свободных радикалов в организме. Безусловно, бывает, что их повышенный уровень – еще не повод делать скоропалительные выводы о какой-то серьезной патологии, напоминают ученые. Ведь активные формы кислорода могут «подскочить» в результате недосыпа, стресса, отравления, острого воспаления. Понять же их взаимосвязь с серьезным хроническим процессом можно только, учитывая другие выявленные факторы состояния организма.
Источник: www.mk.ru
























